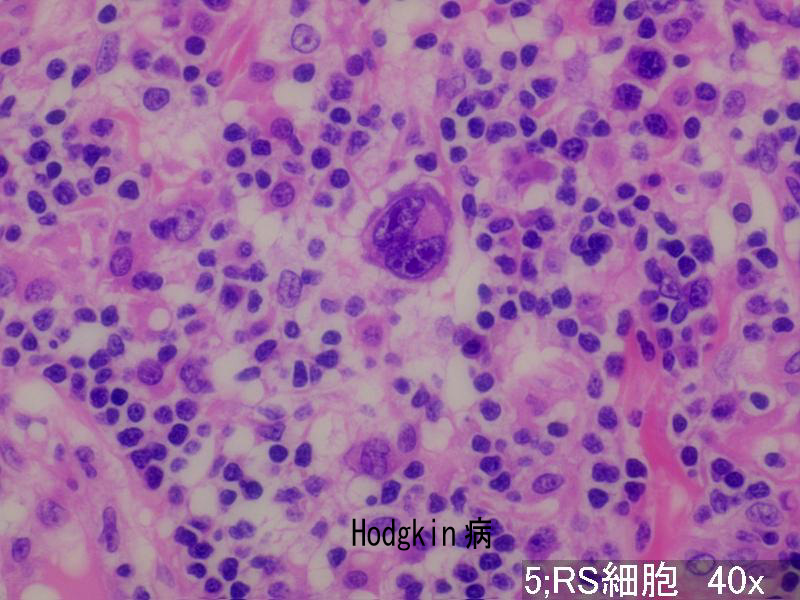

| 第 62 回 日本病理学会東北支部学術集会(JSP
−TN) 抄録データベース |
| 演題番号 |
13 |
区分 |
B. 典型的・教育的・その他の症例 |
| 演題名 |
回腸穿孔で判明したクローン病とホジキン病の合併例 |
| 出題者および所属 |
|
菅原 長弘1 大藤 高志2 森谷 卓也3 高橋 道長1 内藤 広郎1
1みやぎ県南中核病院外科 2同 病理科 3東北大学病院 病理部 |
|
| 症例の概要・問題点 |
| 症例 |
83歳.女性 |
| 主訴 |
腹痛 |
| 既往歴 |
2004年6月,9月,12月に下腹部痛,下痢,発熱で当院消化器科に
入院加療し軽快.2005年4月下腹部痛,貧血で再度入院したが,上
部/下部消化管内視鏡検査で著変認められず.なお,2002年より神
経症として服薬治療中.
|
| 現病歴 |
2005年5月19日朝から強い腹痛があり,昼過ぎに当院救急外来を受
診.腹部全体に筋性防御があり,CTで回腸穿孔が疑われ緊急手術と
なった.回盲部よりおよそ25cmに穿孔があり,盲腸を含めおよそ
70cmが切除された.なお,術前の生化学検査で白血球増多,強い貧
血,CRP高値,低アルブミン血症,BUN高値.
|
| 病理所見と組織診断 |
回腸のマクロでは,手術時に確認された穿孔の他,回腸全域にわた
る長い線状潰瘍と深く大きな不整形潰瘍が3ヵ所で認められ,深い
潰瘍の1つは穿孔していた.ミクロではクローン病とホジキン病の
2つの組織像が認められた.クローン病として,時にfissuringの
明らかな粘膜あるいは粘膜下層までの治癒像をも含む線状潰瘍,全
層性のリンパ球中心の炎症性細胞浸潤が見られ,非乾酪性類上皮細
胞肉芽腫は下記の大きな潰瘍に認められた.後者のホジキン病の所
見は穿孔部と3ヵ所の深く大きな不整形潰瘍近傍で見られ,非腫瘍
性の小型リンパ球等を背景とする多数の大型のReed-Sternberg細胞
とそのvariantはCD30, CD15陽性, EBERとLMP-1陽性であった.以上
より,primary EBV-associated Hodgkin disease of the ileum
complicating Crohn diseaseと診断した.
|
|
|
| 本例の問題点 |
回腸のクローン病とホジキン病合併例は稀で,EBVとの関連を述べ
た論文となると極めて僅かであるが,深く大きな潰瘍形成の成り立
ち,消化管ホジキン病とリンパ装置との関係などについて御教示い
ただきたい.
|
| 最終病理診断 |
Gastrointestinal Hodgkin disease associated with Crohn's disease
(Extranodal EBV-associated B cell lymphoproliferative disorder in the ileumとする意見あり)
|
| 演者診断 |
Hodgkin病+Crohn病 |
| コメント |
回腸にクロ・ン病と古典的ホジキンリンパ腫の像が併存しており,
後者はこれまでに報告されている脳原発,胃原発,直腸原発ホジ
キン病のそれと全く異なる所がないので,回腸のホジキン病とク
ロ・ン病の合併例とした.
なお,本例での慢性免疫異常の存否は不明である.
|
|
|
|
|
|
|
|
|
|
|
|
|
|
|
|
|
|
|
|
|
|
|
画像1
|
画像2
|
|
 |
|
|
|
|
|
|
|
|
|
|
|
|
|
|
|
|
|
|
|
|
|
|
|